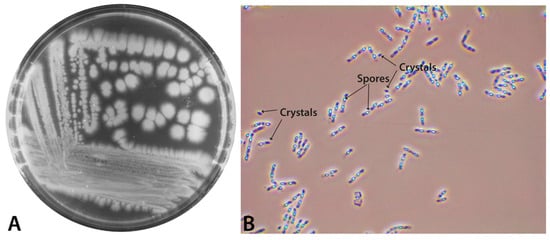

Abstract
Bacillus thuringiensis (Bt) is a Gram-positive, spore-forming, and ubiquitous bacterium harboring plasmids encoding a variety of proteins with insecticidal activity, but also with activity against nematodes. The aim of this work was to perform the genome sequencing and analysis of a native Bt strain showing bipyramidal parasporal crystals and designated V-CO3.3, which was isolated from the dust of a grain storehouse in Córdoba (Spain). Its genome comprised 99 high-quality assembled contigs accounting for a total size of 5.2 Mb and 35.1% G + C. Phylogenetic analyses suggested that this strain should be renamed as Bacillus cereus s.s. biovar Thuringiensis. Gene annotation revealed a total of 5495 genes, among which, 1 was identified as encoding a Cry5Ba homolog protein with well-documented toxicity against nematodes. These results suggest that this Bt strain has interesting potential for nematode biocontrol.
Dataset: The BioSample data have been submitted under accession number SAMN41014059. The whole-genome sequences have been submitted to the NCBI with BioProject number PRJNA1102171. The assembled genome sequences are available under accession number JBCGZW000000000. The (Illumina) raw reads have been submitted to Sequence Read Archives (SRA) under accession number SRR28927673. The V-CO-3.3 strain has been stored in the Spanish Type Culture Collection (CECT) at the University of Valencia (Spain) under accession number CECT 31068.
Dataset License: CC-BY-NC
1. Summary
Bacillus thuringiensis (Bt) is a ubiquitous, Gram-positive, and spore-forming bacterium, capable of producing a variety of proteins with toxic activity against insect pests of different orders, including human-disease vectors (mosquitoes) [1]. Beyond this feature, Bt is also able to produce a sub-group of proteins with toxicity against nematodes of agronomic relevance (e.g., plant-pathogenic nematodes), but also against species of veterinary and human importance (e.g., parasitic disease-causing worms) [2,3,4]. Most of these proteins belong to a major group of proteins known as three-domain crystal proteins, namely Cry5, Cry12, Cry13, Cry14, Cry21, and Cry31 [5,6], plus others, belonging to the App6 class of alpha-helical pesticidal proteins (previously Cry6) and the latter to the Xpp55 class of proteins (previously Cry55), with yet uncharacterized structures [7]. Some of these proteins have shown remarkable nematicidal activities and have become promising tools for the biological control of harmful nematodes [5].
The mode of action of insecticidal Cry proteins, including Xpp proteins from the new nomenclature [7], is generally assumed to produce osmotic shock resulting from the pore-forming action of the Cry protein. This process occurs after the protein is activated by insect midgut proteases and binds to receptors [8]. In the case of nematicidal Cry5 proteins, its mode of action is also generally accepted to behave similarly to that of insecticidal Cry proteins. Glycosphingolipids and the cadherin CDH-8 have been proposed as receptors for Cry5B, as the deletion of both genes in Caenorabditis elegans results in partial resistance to this toxin [9].
In this study, we conducted the whole-genome sequencing analysis of the bacterial strain V-CO3.3 to identify genes associated with biocidal activity and to determine the phylogenetic position of the bacterial strain into the Bacillus cereus group.
2. Data Description
2.1. Isolation and Morphological Characterization of V-CO3.3 Strain
The Bt strain V-CO3.3 was isolated in 1998 from dust from a grain storehouse in the province of Córdoba, Spain [10], and chosen after a comprehensive screening of strains carrying genes coding for nematicidal proteins [11]. The colony incubated for 72 h at 29 °C on CCY agar formed typical Bt colonies showing a matte white color and irregular borders (Figure 1A). The Bt vegetative cells displayed a rod-shaped morphology with subterminal spores along with bipyramidal parasporal crystals (Figure 1B).
Figure 1.
Morphological characterization of Bt strain V-CO3.3. (A) after 72 h of incubation on CCY agar at 29 °C and (B) sporulated colony material exhibiting spores and bipyramidal crystals under a phase-contrast microscope (1000×).
Based on macro- and microscopical morphological analysis, the strain was preliminarily identified as belonging to the B. thuringiensis species and was designated as V-CO3.3. This strain was included in 2024 in the Spanish Type Culture Collection at the University of Valencia (Spain) under accession number CECT 31068.
2.2. Genome Sequencing and Assembly Statistics
The genome sequencing procedure yielded 17,753,390 Illumina paired-end (raw) reads, which were assembled after trimming, generating 99 contig sequences (Table 1). The quality assessment of the genome sequence with ChekM v1.0.18 against Bacillales (Marker Lineage), including 139 genomes and 508 markers, showed a high-quality assembled genome with a completeness of 99.43% and no contamination.

Table 1.
Summary statistics of the V-CO3.3 genome sequence.
2.3. Phylogenetic Analysis and Species Classification Proposal
In order to better identify the species to which the V-CO3.3 strain belongs, a genome-based phylogenetic tree was built using the tool Insert Genome Into SpeciesTree v2.2.0 imbedded into The Department of Energy Systems Biology Knowledgebase (Kbase) [12] (Figure 2).

Figure 2.
The genome-based phylogenetic tree showing the placement of the V-CO3.3 strain (red color) within Bacillus species.
As presented in Figure 2, the V-CO3.3 strain is closely related to the B. cereus-type strain, ATCC 14579, as well as to other species in the B. cereus sensu lato group. The Average Nucleotide Identity (ANI) threshold of 95–96% is commonly used as a reliable criterion for delineating species boundaries [13,14]. The FastANI v0.1.3 [15] software embedded in KBase was used to estimate %ANI relative to other closely related species genomes (Table 2). Since the ANI calculations between two strains retrieve two different reciprocal values, the mean value should be used for taxonomic purposes. The V-CO3.3 strain showed an ANI percentage greater than the established threshold for both B. cereus ATCC 14579 and B. thuringiensis, making species delineation inconsistent (Table 2).

Table 2.
List of ten related assembled genomes from NCBI RefSeq database [16], in comparison with the genome of the V-CO3.3 strain based on estimated %ANI (average nucleotide identity) calculated using FastANI [15]. %ANI is the average of reciprocal values from two compared genome sequences (i.e., B. cereus ATCC 14579 vs. B. thuringiensis ATCC 10792 and B. thuringiensis ATCC 10792 vs. B. cereus ATCC 14579).
Additional comparisons were performed using the OAT program against the genomes of B. cereus ATCC 14579 and B. thuringiensis ATCC 10792, as well as other additional Bt strains (Figure 3). Both ANI and OrthoANI algorithms are comparable, sharing a species demarcation threshold of 95–96%. Similarly, V-CO3.3 showed OAT values greater than the species boundary value (95–96%), which did not allow consistent species delimitation, especially between highly related species such as B. cereus ATCC 14579 and B. thuringiensis ATCC 10792.

Figure 3.
Heatmap displaying the OrthoANI values between the V-CO3.3 strain and closest relative species along with its UPGMA tree. The values are interpreted diagonally. For example, the V-CO3.3 strain showed a 96.76% OAT value against B. thuringiensis ATCC 10792 (indicated by black, arrowed dashed lines).
Finally, an additional phylogenetic study was performed using the Type Strain Genome Server (TYGS) [17], which showed that the V-CO3.3 strain is clustered along with the B. cereus type strain ATCC 14579 and the B. thuringiensis type strain ATCC 10792 in a unique branch (Figure 4).

Figure 4.
Whole-genome sequence-based tree showing the phylogenetic relationship of the V-CO3.3 strain with other type species strains (97.4% average branch support). Green color was used to highlight the V-CO3.3 strain, which clustered with closely related type strains.
The TYGS also showed a digital DNA-DNA hybridization (dDDH) value of 91% and a difference in the G + C content of 0.17% compared to the B. cereus ATCC 14579-type strain (Table 3). The dDDH value of 91% of our strain compared to B. cereus ATCC 14579 is above the 70% cut-off. This indicates that the V-CO3.3 strain is highly similar to B. cereus ATCC 14579 and likely belongs to the same species. Additionally, the G + C content difference of 0.17% supports this conclusion, as it is within the expected range of variation (no more than 1%) for strains of the same species.

Table 3.
Pairwise dDDH (DNA-DNA hybridization) values between the V-CO3.3 genome and the type strain genomes selected by TYGS. The dDDH values are shown, including their confidence intervals (C.I.) for the d4 formula (d4 is independent of genome size and therefore robust when using draft genomes) [17].
This cluster is consistent with the new classification proposed by Carroll et al. (2020), which denoted that most of the biovar Thuringiensis isolates, including the type strain B. thuringiensis serovar Berliner ATCC 10792, belong to the B. cereus sensu stricto group. Therefore, based on these data, it was concluded that the V-CO3.3 strain should be renamed as B. cereus s.s. biovar Thuringiensis [18].
2.4. Genome Analysis and Annotation
The NCBI Prokaryotic Genome Annotation Pipeline (PGAP) found a total of 5234 protein-coding genes (Table 4). These findings are consistent with the size and % G + C already observed in other sequenced genomes of B. thuringiensis obtained from the GenBank database [19].

Table 4.
Summary of the NCBI Prokaryotic Genome Annotation.
The genome was also annotated with the RAST server which allowed the detection of chitinase enzymes. These enzymes should play a role in insect pathogenesis because they hydrolyze chitin, a major component of the insect exoskeleton and nematode cuticle [20].
Custom searches of potentially invertebrate-active genes showed the presence of a single CDS encoding a protein with 100% identity with Cry5Ba2 at contig 64, highlighting that, interestingly, the V-CO3.3 strain is monogenic for cry genes. Cry5 proteins are well known for their nematicidal activity against mammalian parasitic worms (e.g., Ascaris sp.) and plant-parasitic nematodes (e.g., Meloydogines incognita) [5,21].
In addition, custom BLAST searches conducted to detect the thuE gene involved in the synthesis pathway of β-exotoxin failed, suggesting that the V-CO3.3 strain should not be able to produce β-exotoxin, a secretable, harmful, wide-spectrum toxin produced by some Bt strains [22].
The genome of the V-CO3.3 strain was also screened for clusters with the potential to produce secondary metabolites with biological activity using antiSMASH [23] (Table 5). Fengycin is a lipopeptide (a betalactone that contains a protease inhibitor) with antifungal activity [24], whereas bacillibactin has demonstrated antibiotic effects when produced by some strains of Bacillus amyloliquefaciens [25]. In contrast, petrobactin has been described to behave as a siderophore [26], while terpene has been described to possess both antagonistic and beneficial effects in different organisms [27]. No clusters potentially related to both insecticidal and nematicidal activity were found using antiSMASH.

Table 5.
Predicted biosynthetic gene clusters in the V-CO3.3 genome and % similarity found by antiSMASH.
Genomic analysis of the B. thuringiensis V-CO3.3 strain has revealed its potential for nematode biocontrol, highlighting a single gene encoding a Cry5Ba homolog protein, which is known for its nematicidal properties. Despite these promising genetic findings, it is crucial to perform in vivo experiments to verify the effectiveness of this strain as active against nematodes. This step is essential for validating the findings of this genomic study and ultimately contributing to the development of sustainable pest management strategies.
3. Methods
3.1. Strain Isolation, Growing Conditions, and Strain Identification
The strain was isolated from dust from a grain storehouse in Córdoba province, Spain and grown in CCY medium [28] at 29 °C for 48–72 h until sporulation occurred to perform the macroscopic characterization [8]. The colony was also analyzed under a phase-contrast microscope, Leica DM 2000 LED (Leica, Wetzlar y Mannheim, Germany), to confirm the presence of parasporal crystals using the 1000× objective (Figure 1B).
3.2. DNA Extraction, Library Construction, and DNA Genome Sequencing
The strain was grown overnight in liquid LB medium (labkem, Barcelona, Spain) at 29 °C with shaking (200 rpm). Total DNA, including the chromosome and plasmids (if any), was extracted using the Wizard genomic DNA purification kit from Promega (Madison, WI, USA) following the manufacturer’s protocol for Gram-positive bacterial DNA extraction. DNA quality and concentration were assessed using 1% agarose gel electrophoresis and a Nanodrop 2000 Spectrophotometer from Thermo Scientific (Waltham, MA, USA), respectively. The purified DNA sample (2.5 μg/mL, A260/280 = 1.98) was then sent to Novogen (Cambridge, UK) to construct a pooled Illumina library by using the Novogene NGS DNA Library Prep Set kit (Cat No. PT004, Novogene, Cambridge, UK) and sequencing using a high-throughput Illumina sequencing platform (Illumina Sequencing PE150).
3.3. Genome Assembly, Sequence Analysis, and Annotation
The de novo genome assembly was conducted over previously trimmed (raw) reads, using the Velvet v1.2.10 assembler tool included in the Geneious R11 software suite (www.geneious.com, accessed on 7 May 2024) with default parameters. The completeness of the assembled genomic sequence and the presence of potential contaminating reads were assessed with CheckM v1.0.18 [29] included in Kbase [12].
Phylogenetic analyses and classification were performed by using three different approaches: (i) the application Insert Genome Into SpeciesTree v2.2.0 from KBase [12], (ii) the OAT (OrthoANI) tool [30], and (iii) the Type Strain Genome Server (TYGS) [17]. SpeciesTree v2.2.0 is useful for constructing a species tree by using a collection of 49 fundamental, universally acknowledged genes delineated by COG (Clusters of Orthologous Groups) gene families: The app merged the studied genome sequence with a curated assortment of closely related genome sequences from the public KBase genome collection imported from NCBI RefSeq database. OAT uses Orthologous Average Nucleotide Identity (OrthoANI) to estimate the overall similarity between two genome sequences. TYGS is a bioinformatics tool designed for the rapid and accurate determination of the taxonomic position of bacterial and archaeal genomes.
The genome was annotated using the automated NCBI Prokaryotic Genome Annotation Pipeline (PGAP) (2024, release) [31] and the RAST server [32], but also by using an in-house custom BLAST [33] database, including known pesticidal proteins obtained and available from the Bacterial Pesticidal Protein Database (https://bpprc-db.org, accessed on 7 May 2024) [34].
A secondary metabolite cluster search was also performed to predict the potential presence of genes involved in bioactive compounds synthesis pathways using antiSMASH [23].
Author Contributions
Conceptualization, L.P., Y.B. and B.E.; methodology, L.P., Y.B. and B.E.; software, L.P.; validation, L.P., Y.B. and B.E.; formal analysis, L.P., Y.B. and B.E.; investigation, L.P., Y.B. and B.E.; resources, B.E.; data curation, L.P.; writing—original draft preparation, L.P.; writing—review and editing, L.P., Y.B. and B.E.; visualization, L.P., Y.B. and B.E.; supervision, B.E.; project administration, B.E.; funding acquisition, B.E. All authors have read and agreed to the published version of the manuscript.
Funding
This research was funded by the Generalitat Valenciana grant (PROMETEO/2020/010). This work was supported by the European Union’s Horizon 2020 Research and Innovation program under Grant Agreement no. 773554 (EcoStack Project).
Institutional Review Board Statement
Not applicable.
Informed Consent Statement
Not applicable.
Data Availability Statement
This whole-genome shotgun project has been deposited in DDBJ/ENA/GenBank under accession number JBCGZW000000000. The version described in this paper is the first version JBCGZW010000000. Illumina paired-end (raw) reads were deposited in the Sequence Read Archive (SRA) database under accession number SRR28927673.
Acknowledgments
Leopoldo Palma would like to express gratitude to the Spanish Government-Universities Ministry, the Next Generation EU, and Recovery, Transformation, and Resilience plans for funding his awarded María Zambrano contract (ref. ZA21-003).
Conflicts of Interest
The authors declare no conflicts of interest.
References
- Palma, L.; Muñoz, D.; Berry, C.; Murillo, J.; Caballero, P. Bacillus thuringiensis toxins: An overview of their biocidal activity. Toxins 2014, 6, 3296–3325. [Google Scholar] [CrossRef] [PubMed]
- Zheng, Z.; Zheng, J.; Zhang, Z.; Peng, D.; Sun, M. Nematicidal spore-forming Bacilli share similar virulence factors and mechanisms. Sci. Rep. 2016, 6, 31341. [Google Scholar] [CrossRef] [PubMed]
- Ruan, L.; Crickmore, N.; Peng, D.; Sun, M. Are nematodes a missing link in the confounded ecology of the entomopathogen Bacillus thuringiensis? Trends Microbiol. 2015, 23, 341–346. [Google Scholar] [CrossRef]
- Bel, Y.; Galeano, M.; Baños-Salmeron, M.; Escriche, B. The use of Bacillus thuringiensis to control plant-parasitic nematodes. J. Plant Sci. Phytopathol. 2022, 6, 62–64. [Google Scholar]
- Jouzani, G.S.; Valijanian, E.; Sharafi, R. Bacillus thuringiensis: A successful insecticide with new environmental features and tidings. Appl. Microbiol. Biotechnol. 2017, 101, 2691–2711. [Google Scholar] [CrossRef] [PubMed]
- Liang, Z.; Ali, Q.; Wang, Y.; Mu, G.; Kan, X.; Ren, Y.; Manghwar, H.; Gu, Q.; Wu, H.; Gao, X. Toxicity of Bacillus thuringiensis Strains Derived from the Novel Crystal Protein Cry31Aa with High Nematicidal Activity against Rice Parasitic Nematode Aphelenchoides besseyi. Int. J. Mol. Sci. 2022, 23, 8189. [Google Scholar] [CrossRef] [PubMed]
- Crickmore, N.; Berry, C.; Panneerselvam, S.; Mishra, R.; Connor, T.R.; Bonning, B.C. A structure-based nomenclature for Bacillus thuringiensis and other bacteria-derived pesticidal proteins. J. Invertebr. Pathol. 2020, 186, 107438. [Google Scholar] [CrossRef] [PubMed]
- Bravo, A.; Pacheco, S.; Gómez, I.; Soberón, M. Chapter Two—Mode of Action of Bacillus thuringiensis Cry Pesticidal Proteins. In Advances in Insect Physiology; Jurat-Fuentes, J.L., Ed.; Academic Press: Cambridge, MA, USA, 2023; Volume 65, pp. 55–92. [Google Scholar]
- Williams, P.D.E.; Brewer, M.T.; Aroian, R.V.; Robertson, A.P.; Martin, R.J. The nematode (Ascaris suum) intestine is a location of synergistic anthelmintic effects of Cry5B and levamisole. PLoS Pathog. 2024, 20, e1011835. [Google Scholar] [CrossRef]
- Iriarte, J.; Bel, Y.; Ferrandis, M.D.; Andrew, R.; Murillo, J.; Ferré, J.; Caballero, P. Environmental distribution and diversity of Bacillus thuringiensis in Spain. Syst. Appl. Microbiol. 1998, 21, 97–106. [Google Scholar] [CrossRef]
- Bel, Y.; Andrés-Antón, M.; Escriche, B. Abundance, distribution, and expression of nematicidal crystal protein genes in Bacillus thuringiensis strains from diverse habitats. Int. Microbiol. 2023, 26, 295–308. [Google Scholar] [CrossRef]
- Arkin, A.P.; Cottingham, R.W.; Henry, C.S.; Harris, N.L.; Stevens, R.L.; Maslov, S.; Dehal, P.; Ware, D.; Perez, F.; Canon, S.; et al. KBase: The United States Department of Energy Systems Biology Knowledgebase. Nat. Biotechnol. 2018, 36, 566–569. [Google Scholar] [CrossRef] [PubMed]
- Richter, M.; Rosselló-Móra, R. Shifting the genomic gold standard for the prokaryotic species definition. Proc. Natl. Acad. Sci. USA 2009, 106, 19126–19131. [Google Scholar] [CrossRef] [PubMed]
- Goris, J.; Konstantinidis, K.T.; Klappenbach, J.A.; Coenye, T.; Vandamme, P.; Tiedje, J.M. DNA-DNA hybridization values and their relationship to whole-genome sequence similarities. Int. J. Syst. Evol. Microbiol. 2007, 57, 81–91. [Google Scholar] [CrossRef] [PubMed]
- Jain, C.; Rodriguez-R., L.M.; Phillippy, A.M.; Konstantinidis, K.T.; Aluru, S. High throughput ANI analysis of 90K prokaryotic genomes reveals clear species boundaries. Nat. Commun. 2018, 9, 5114. [Google Scholar] [CrossRef] [PubMed]
- O’Leary, N.A.; Wright, M.W.; Brister, J.R.; Ciufo, S.; Haddad, D.; McVeigh, R.; Rajput, B.; Robbertse, B.; Smith-White, B.; Ako-Adjei, D.; et al. Reference sequence (RefSeq) database at NCBI: Current status, taxonomic expansion, and functional annotation. Nucleic Acids Res. 2016, 44, D733–D745. [Google Scholar] [CrossRef] [PubMed]
- Meier-Kolthoff, J.P.; Göker, M. TYGS is an automated high-throughput platform for state-of-the-art genome-based taxonomy. Nat. Commun. 2019, 10, 2182. [Google Scholar] [CrossRef] [PubMed]
- Carroll, L.M.; Wiedmann, M.; Kovac, J. Proposal of a Taxonomic Nomenclature for the Bacillus cereus Group Which Reconciles Genomic Definitions of Bacterial Species with Clinical and Industrial Phenotypes. mBio 2020, 11, e00034-20. [Google Scholar] [CrossRef] [PubMed]
- Sayers, E.W.; Cavanaugh, M.; Clark, K.; Pruitt, K.D.; Schoch, C.L.; Sherry, S.T.; Karsch-Mizrachi, I. GenBank. Nucleic Acids Res. 2021, 49, D92–D96. [Google Scholar] [CrossRef] [PubMed]
- Patel, S.; Goyal, A. Chitin and chitinase: Role in pathogenicity, allergenicity and health. Int. J. Biol. Macromol. 2017, 97, 331–338. [Google Scholar] [CrossRef]
- Van Frankenhuyzen, K. Insecticidal activity of Bacillus thuringiensis crystal proteins. J. Invertebr. Pathol. 2009, 101, 1–16. [Google Scholar] [CrossRef]
- Sauka, D.H.; Pérez, M.P.; López, N.N.; Onco, M.I.; Berretta, M.F.; Benintende, G.B. PCR-based prediction of type I β-exotoxin production in Bacillus thuringiensis strains. J. Invertebr. Pathol. 2014, 122, 28–31. [Google Scholar] [CrossRef] [PubMed]
- Blin, K.; Pascal Andreu, V.; de Los Santos, E.L.C.; Del Carratore, F.; Lee, S.Y.; Medema, M.H.; Weber, T. The antiSMASH database version 2: A comprehensive resource on secondary metabolite biosynthetic gene clusters. Nucleic Acids Res. 2019, 47, D625–D630. [Google Scholar] [CrossRef] [PubMed]
- Vanittanakom, N.; Loeffler, W.; Koch, U.; Jung, G. Fengycin—A novel antifungal lipopeptide antibiotic produced by Bacillus subtilis F-29-3. J. Antibiot. Tokyo 1986, 39, 888–901. [Google Scholar] [CrossRef]
- Dimopoulou, A.; Theologidis, I.; Benaki, D.; Koukounia, M.; Zervakou, A.; Tzima, A.; Diallinas, G.; Hatzinikolaou, D.G.; Skandalis, N. Direct Antibiotic Activity of Bacillibactin Broadens the Biocontrol Range of Bacillus amyloliquefaciens MBI600. mSphere 2021, 6, e0037621. [Google Scholar] [CrossRef] [PubMed]
- Bergeron, R.J.; Huang, G.; Smith, R.E.; Bharti, N.; McManis, J.S.; Butler, A. Total synthesis and structure revision of petrobactin. Tetrahedron 2003, 59, 2007–2014. [Google Scholar] [CrossRef]
- Gershenzon, J.; Dudareva, N. The function of terpene natural products in the natural world. Nat. Chem. Biol. 2007, 3, 408–414. [Google Scholar] [CrossRef] [PubMed]
- Stewart, G.S.; Johnstone, K.; Hagelberg, E.; Ellar, D.J. Commitment of bacterial spores to germinate. A measure of the trigger reaction. Biochem. J. 1981, 198, 101–106. [Google Scholar] [CrossRef] [PubMed]
- Parks, D.H.; Imelfort, M.; Skennerton, C.T.; Hugenholtz, P.; Tyson, G.W. CheckM: Assessing the quality of microbial genomes recovered from isolates, single cells, and metagenomes. Genome Res. 2015, 25, 1043–1055. [Google Scholar] [CrossRef] [PubMed]
- Lee, I.; Ouk Kim, Y.; Park, S.C.; Chun, J. OrthoANI: An improved algorithm and software for calculating average nucleotide identity. Int. J. Syst. Evol. Microbiol. 2016, 66, 1100–1103. [Google Scholar] [CrossRef]
- Tatusova, T.; DiCuccio, M.; Badretdin, A.; Chetvernin, V.; Nawrocki, E.P.; Zaslavsky, L.; Lomsadze, A.; Pruitt, K.D.; Borodovsky, M.; Ostell, J. NCBI prokaryotic genome annotation pipeline. Nucleic Acids Res. 2016, 44, 6614–6624. [Google Scholar] [CrossRef]
- Aziz, R.K.; Bartels, D.; Best, A.A.; DeJongh, M.; Disz, T.; Edwards, R.A.; Formsma, K.; Gerdes, S.; Glass, E.M.; Kubal, M.; et al. The RAST Server: Rapid annotations using subsystems technology. BMC Genom. 2008, 9, 75. [Google Scholar] [CrossRef] [PubMed]
- Altschul, S.F.; Gish, W.; Miller, W.; Myers, E.W.; Lipman, D.J. Basic local alignment search tool. J. Mol. Biol. 1990, 215, 403–410. [Google Scholar] [CrossRef] [PubMed]
- Panneerselvam, S.; Mishra, R.; Berry, C.; Crickmore, N.; Bonning, B.C. BPPRC database: A web-based tool to access and analyse bacterial pesticidal proteins. Database 2022, 2022, baac022. [Google Scholar] [CrossRef] [PubMed]
Disclaimer/Publisher’s Note: The statements, opinions and data contained in all publications are solely those of the individual author(s) and contributor(s) and not of MDPI and/or the editor(s). MDPI and/or the editor(s) disclaim responsibility for any injury to people or property resulting from any ideas, methods, instructions or products referred to in the content. |
© 2024 by the authors. Licensee MDPI, Basel, Switzerland. This article is an open access article distributed under the terms and conditions of the Creative Commons Attribution (CC BY) license (https://creativecommons.org/licenses/by/4.0/).